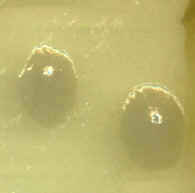

Tour of Microbes  Tour Home | Disease Home | Microbes A to Z | Bio 203 Home |
Escherichia coli with pili
E. coli colonies on TSA
Escherichia are Gram - negative rods, approx. 1 x 2 um in size, commonly found in the intestinal tracts of warm-blooded animals. Most strains are harmless or beneficial, but several are considered to be enteropathogenic, including the infamous E. coli O157:H7. Escherichia are chemoheterotrophic and facultative anaerobes, capable of fermenting a variety of sugars. Escherichia are members of the Enterobacteria and closely related to Proteus, Klebsiella, and Citrobacter.
Domain Bacteria
Phylum Proteobacteria
Class γ - Proteobacteria
Family Enterobacteriaceae
Bergey's Manual Volume 2: The Proteobacteria
Facultative anaerobe: oxidase-negative, catalase-positive, nitrate-positive
Metabolism: respiratory and fermentative , Acid/Gas from glucose and lactose, MR-positive, VP-negative
Other tests: indole-positive, citrate-negative, H2S-negative
Hydrolysis: amylase-negative, some strains casease-positive, DNAse-negative,, gelatinase-negative
Structure: some strains (K12) motile